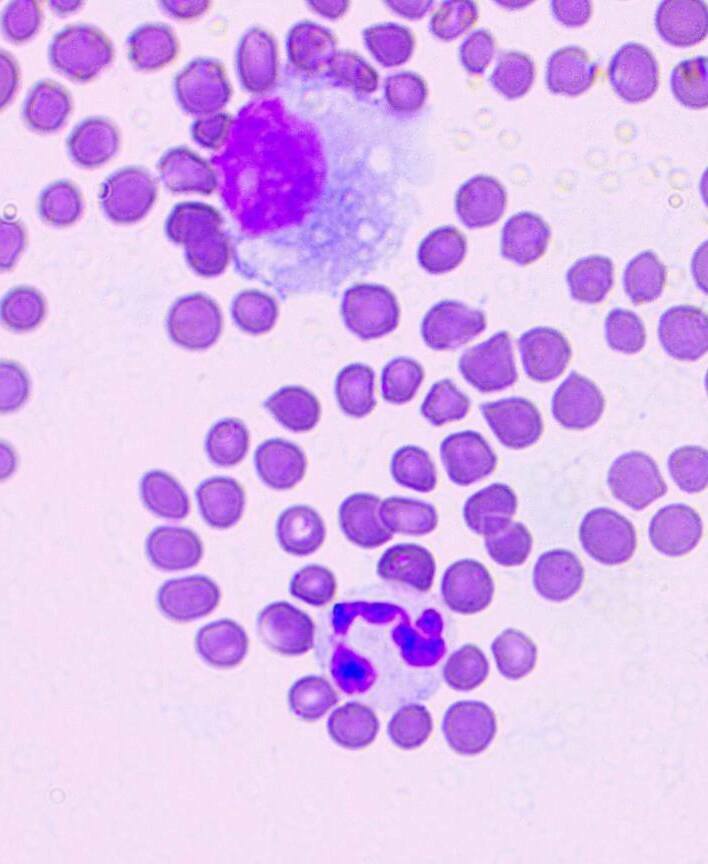
Анализ крови, проведенный в лаборатории ветеринарной клинике "Лапа Помощи"

- 8(988)242-82-29
- г. Краснодар, ул. Архитектора Ишунина, 7/1 корпус 2
- info@lapaclinic.ru
Lapaclinic.ru
Лаборатория при ветеринарной клинике "лапа помощи"
Собственная ветеринарная лаборатория при клинике "Лапа Помощи" — это место, где современные технологии и опыт специалистов объединяются ради здоровья вашего питомца.
Мы проводим широкий спектр лабораторных исследований для животных:
— анализ крови, мочи, кала,
— цитологию, кожные и ушные соскобы,
— а также инструментальные исследования — отоскопию, офтальмоскопию, риноскопию, люминесцентную и ультразвуковую диагностику.
Благодаря собственной лаборатории мы сокращаем время получения результатов, снижаем стоимость анализов и гарантируем достоверность данных.
Все процедуры выполняются на современном оборудовании, что позволяет точно диагностировать заболевания и начать лечение без ожидания.
Если вам нужно сдать анализы животному быстро, безопасно и по доступной цене — вы можете сделать это прямо в нашей клинике.
Мы заботимся о каждом пациенте и уверены: качественная диагностика — основа успешного лечения.
Основные виды анализов в ветеринарной клинике "Лапа Помощи"
Общий клинический анализ крови
Биохимический анализ крови
ПЦР-исследования:
ИФА-исследования:
Зачем животным нужны анализы и когда их стоит сдавать?
Регулярные лабораторные исследования животных — это основа точной диагностики и профилактики заболеваний.
Многие болезни у кошек и собак развиваются незаметно, без выраженных симптомов, и именно анализы помогают выявить проблему на ранней стадии, когда лечение наиболее эффективно.
Когда нужно сдавать анализы питомцу:
- перед вакцинацией, операцией или плановым осмотром;
- при изменении аппетита, поведения, потере веса;
- если появились вялость, рвота, понос, зуд или выделения;
- для контроля лечения хронических заболеваний;
- при профилактическом обследовании — не реже одного раза в год.
Своевременно проведённые анализы крови, мочи, кала и другие исследования позволяют врачу-ветеринару точно определить причину недомогания, подобрать правильное лечение и сохранить здоровье питомца.
Как подготовить животное к сдаче анализов?
Кровь сдаётся строго натощак — за 8–12 часов до процедуры животному нельзя давать пищу, но воду разрешено (ОАК сдаётся без голодной диеты).
Перед анализом мочи и кала желательно собрать материал утром, в чистую ёмкость, без примесей наполнителя или песка(с момента сбора биоматериалов и до доставки в клинику должно пройти не более одного часа либо допускается хранение в условиях холодильника и до доставки в клинику до 12 часов.
За 1–2 дня исключите из рациона жирную пищу, витамины и лекарства (если иное не рекомендовано ветеринаром).
Старайтесь сохранять спокойствие питомца: стресс влияет на результаты анализов.
Лаборатория оснащена высокотехнологичным современным оборудованием:
ПОПУЛЯРНЫЕ ВОПРОСЫ
Какие анализы чаще всего назначают животным?
Сколько времени занимает выполнение анализов?
Какие анализы требуются перед вакцинацией или операцией?
Можно ли сдавать анализы без назначения ветеринара?
Какие анализы позволяют выявить аллергии у кошек и собак?
Какие анализы позволяют выявить скрытые инфекции у кошек и собак?